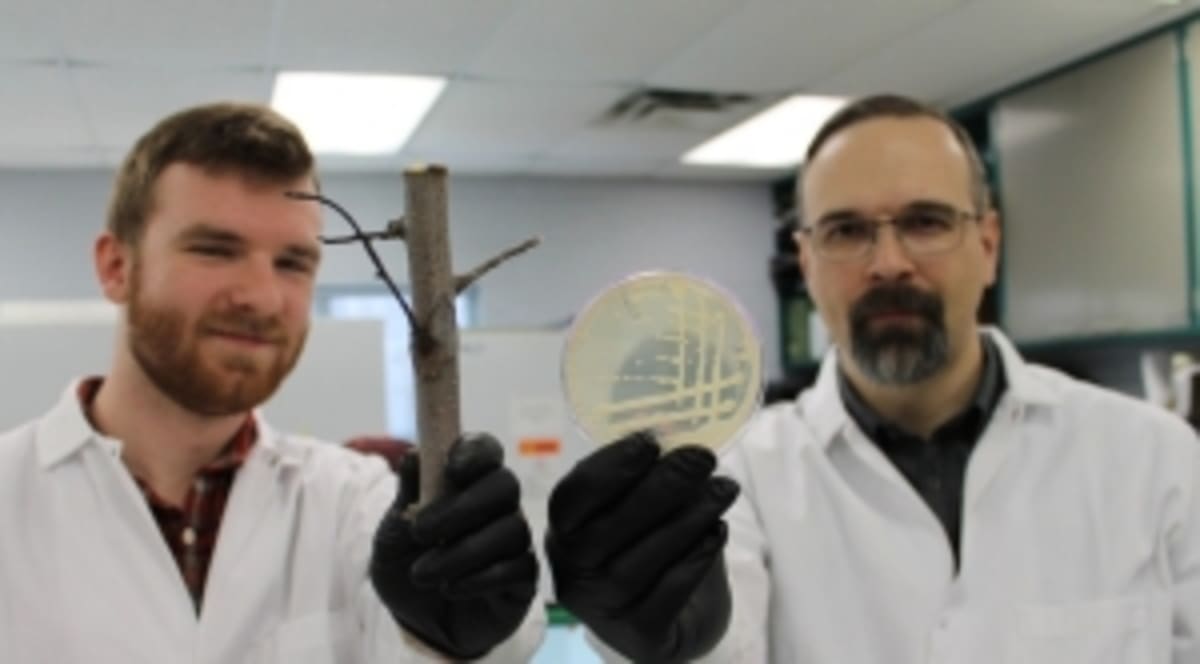
Pennsylvania Fruit Growers Launch $3,000 Scholarship - Image 4

Pennsylvania Fruit Growers Launch $3,000 Scholarship
A Pennsylvania agricultural group is offering scholarships starting at $3,000 to students pursuing careers in the state's fruit industry. The program honors a beloved fruit grower known for lifting up his community.
Students dreaming of careers in Pennsylvania's orchards now have a new path to make it happen, thanks to a scholarship honoring a fruit grower who spent his life helping others succeed.
The State Horticultural Association of Pennsylvania just opened applications for the Scott Brown Memorial Scholarship for the 2026-2027 academic year. The award starts at $3,000 and supports students pursuing careers in Pennsylvania's fruit industry.
Scott Brown was a fruit grower who became known throughout his community for encouraging others and showing genuine leadership. He served on research and endowment fund committees and led the York Fruit Growers Association as president, always looking for ways to strengthen the industry he loved.
The scholarship welcomes both high school seniors and current college students who are enrolled full time at universities, colleges, community colleges, or trade schools. Students don't need to demonstrate financial need, but they will be judged on their grades, community involvement, leadership skills, and vision for contributing to Pennsylvania's fruit industry.

Applications are due by May 1, 2026, and winners will hear the good news by June 15. Students can get applications by contacting the association in York Springs or downloading one from the SHAP website.
The Ripple Effect
This scholarship does more than help individual students pay for school. It plants seeds for the future of Pennsylvania agriculture, ensuring the next generation has the skills and passion to keep orchards thriving across the state.
The association is also inviting individuals, companies, and organizations to contribute to the scholarship fund. Every donation means more students can follow their dreams of working in the fruit industry while carrying forward Scott Brown's legacy of supporting others.
Pennsylvania's fruit growers are investing in tomorrow by helping students today.
More Images

Based on reporting by Google News - Scholarship Awarded
This story was written by BrightWire based on verified news reports.
Spread the positivity!
Share this good news with someone who needs it

